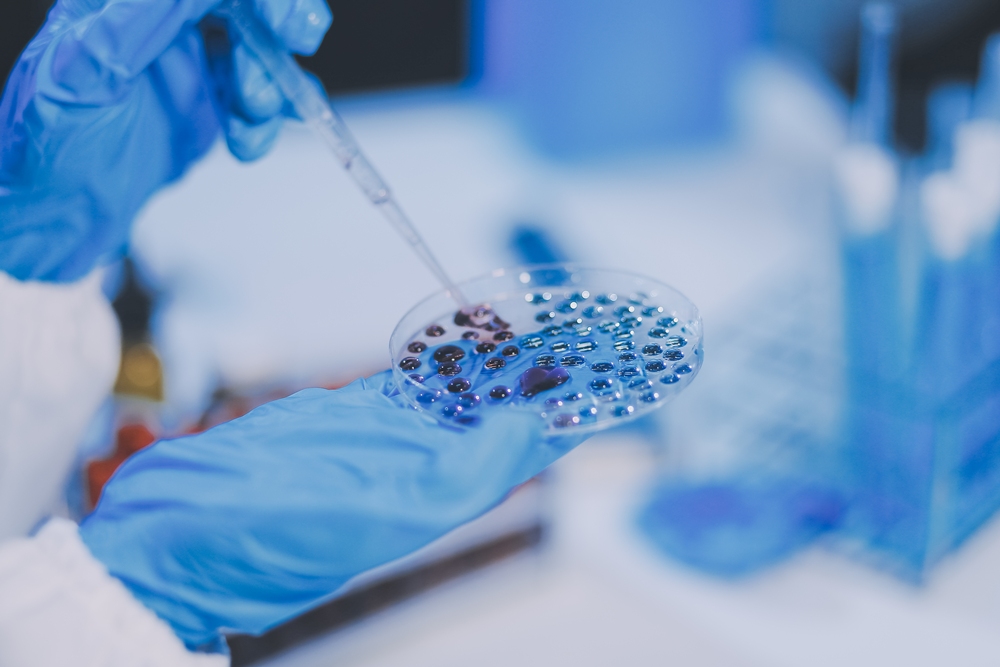
ErVimmune raises €17m for cancer vaccines

News by region
ErVimmune has announced a first closing of a €17m Series A to develop cancer vaccines for ‘cold tumours’ that often fail to respond to immunotherapies. The Lyon-based biotech is developing therapeutic vaccines and cell therapies for cold tumours, a term used for cancers that tend to evade immune-based treatments. The funding will support clinical development [...]
Kinaset Therapeutics has raised US$103m in a Series B to move forward frevecitinib, an inhaled asthma therapy for people not controlled by standard inhalers. The Boston-based firm is developing an inhaled treatment for serious respiratory diseases. The company will use the proceeds to advance frevecitinib, an inhaled dry powder being developed for people whose asthma [...]
Why the real return on JPM, HIMSS, HLTH, and Davos is earned after the agenda, when leaders turn access into action By Gil Bashe, chair global health and purpose at FINN Partners and Health Tech World correspondent In the days following JPM Healthcare Week, one pattern comes into focus with unusual clarity. The important work [...]
QV Bioelectronics has secured £4.5m in investment and grant funding to develop what it calls a world-first glioblastoma implant. Cheshire-based medtech QV Bioelectronics said the funding will support an implantable device intended to improve outcomes for patients with glioblastoma. Glioblastoma, or GBM, is an aggressive brain tumour. Cancer Research UK says it accounted for about [...]
Eolas Medical has raised US$12m in series A funding to scale its AI search tools within the NHS. Its platform is already used at more than 400 clinical sites in the UK, according to the company. The Northern Irish health-tech start-up said its AI search platform aims to provide “point-of-care knowledge tools supporting clinical safety, [...]
Primary care digital front door supplier X-on Health, in partnership with delivery partner TORTUS, has been confirmed as one of the first self-certified suppliers on the newly launched NHS England Ambient Voice Technology (AVT) Registry. The confirmation recognises the use of X-on Health’s Surgery Intellect incorporating ambient voice capability using TORTUS technology, supporting GP practices [...]
SuperLiving has secured US$2m in funding to help expand the wellbeing platform across India. The round was led by Kae Capital, with participation from All In Capital and other angel investors. The start-up previously secured Rs 2 crore (about US$230,000) from All In Capital in September 2025 after winning the ‘Elevator Pitch’ event. [...]
Hong Kong-listed Zylox-Tonbridge has agreed to acquire German medtech Optimed, in a deal aimed at speeding up its international expansion. Under the agreement, Zylox-Tonbridge will acquire Optimed’s equity interest in multiple steps, with an option to purchase the entire shareholding from the current owners. Zylox-Tonbridge specialises in neurovascular and peripheral vascular interventional products, medical devices [...]
By David Gibbs, pathology network director at Peninsula Pathology Network The ongoing transformation of the pathology sector is driven by rising demand for faster and more accurate diagnosis, workforce pressures and policy reform. It is continually being reshaped by rapid advancements in technology and the introduction of artificial intelligence (AI) promises next level accuracy and [...]
The Blood Transfusion service at Aneurin Bevan University Health Board has gone live with Clinisys WinPath in a first of type deployment in Wales. The service is a long-standing user of Clinisys Laboratory Information Management Systems (LIMS), but its LabCentre LIMS had reached end of life. Clinisys worked with ABUHB to make sure the latest [...]